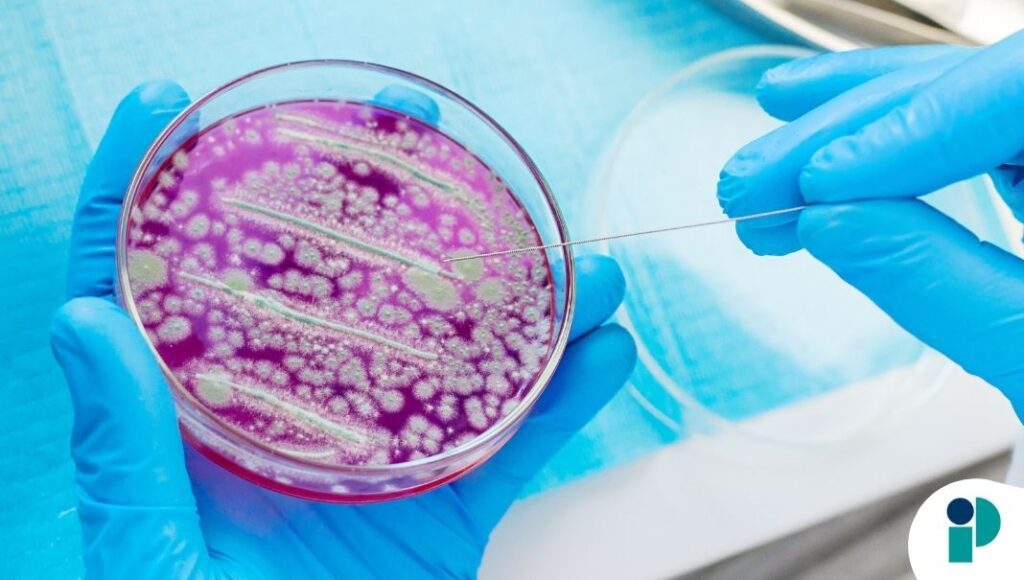
original web (33)

Un estudio reciente del Instituto Karolinska, en Suecia, confirma que el virus de Epstein-Barr (VEB), responsable de la mononucleosis infecciosa o “enfermedad del beso”, puede desencadenar una respuesta inmunitaria capaz de dañar el cerebro y contribuir al desarrollo de la esclerosis múltiple (EM). Los hallazgos fueron publicados en la revista científica Cell.
Una hipótesis que gana respaldo científico
Durante años, la comunidad científica ha investigado la posible relación entre el virus de Epstein-Barr y la esclerosis múltiple, una enfermedad inflamatoria crónica del sistema nervioso central que afecta a cerca de tres millones de personas en el mundo y que, hasta el momento, no tiene cura.
Aunque se sabía que prácticamente todas las personas que desarrollan esclerosis múltiple han estado previamente infectadas por el VEB, no estaba claro cómo este virus contribuía al daño neurológico. La nueva investigación aporta evidencia clave que ayuda a explicar este vínculo.
El estudio revela que, al combatir el virus de Epstein-Barr, ciertas células T encargadas de defender al organismo pueden reaccionar de forma cruzada y atacar una proteína del cerebro llamada anoctamina-2 (ANO2). Este fenómeno, conocido como mimetismo molecular, hace que el sistema inmunitario confunda proteínas propias con las del virus.
Los investigadores encontraron que estas células T con reacción cruzada son significativamente más frecuentes en personas con esclerosis múltiple que en individuos sanos.
“Nuestros resultados proporcionan pruebas mecanicistas de que las respuestas inmunitarias al virus pueden dañar directamente el cerebro en la esclerosis”, explicó Olivia Thomas, primera autora del estudio y científica del Departamento de Neurociencia Clínica del Instituto Karolinska.
Para llegar a estas conclusiones, el equipo analizó muestras de sangre de personas con esclerosis múltiple y las comparó con las de personas sanas. Lograron aislar células T que reaccionaban tanto a la proteína EBNA1 del virus como a la ANO2 del cerebro.
Además, experimentos realizados en modelos de ratón demostraron que estas células inmunitarias pueden agravar síntomas similares a los de la esclerosis múltiple y causar daño cerebral, reforzando la hipótesis de un vínculo directo entre la infección viral y la enfermedad neurológica.
Implicaciones para nuevos tratamientos
Los autores del estudio señalan que estos hallazgos ayudan a entender por qué solo algunas personas desarrollan esclerosis múltiple tras una infección por el virus de Epstein-Barr, mientras que otras no.
Aunque actualmente no existe una forma eficaz de prevenir o tratar la infección por este virus, los científicos consideran que una vacuna contra el VEB o el uso de fármacos antivirales específicos podría convertirse en una estrategia clave para prevenir o incluso tratar la esclerosis múltiple en el futuro.
“Este descubrimiento abre la puerta a nuevos tratamientos dirigidos específicamente a estas células inmunitarias con reacción cruzada”, afirmó Tomas Olsson, codirector del estudio junto a Andre Ortlieb Guerreiro-Cacais. Ambos destacan que, dado que ya existen vacunas y antivirales contra el VEB en fase de ensayo clínico, los resultados podrían tener un impacto significativo en los esfuerzos preventivos y terapéuticos a largo plazo.
Fuente original aquí